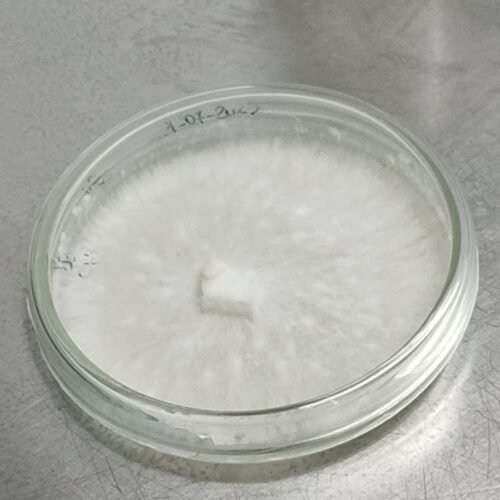
Cultura Pura | Várias Espécies

Os Cogumelos Mais Frescos
Colhidos Localmente, Saboreados com Excelência!
Portes Grátis
Encomendas superiores a 50€
Qualidade garantida
Entrega rápida
Entrega 1-3 dias úteis
Pagamento seguro
Seus dados estão protegidos
Golden Cap
Sobre Nós
Em 2018, iniciaram-se as primeiras experiências de produção de cogumelos de uma forma sustentável. Foi neste ano que se testaram diversas matérias-primas locais e nacionais para a produção de cogumelos. Foram realizados muitos testes com resultados diferentes na produção e qualidade dos cogumelos.
Alguns dos nossos produtos
-
PROMOÇÃO !!! 
Meio de Cultura | MEA | Placas Petri
10,00 € – 30,00 €Price range: 10,00 € through 30,00 €Ver opções This product has multiple variants. The options may be chosen on the product page -
PROMOÇÃO !!! 
Cogumelo Shiitake | Fresco
7,50 € – 130,00 €Price range: 7,50 € through 130,00 €Ver opções This product has multiple variants. The options may be chosen on the product page -
PROMOÇÃO !!! 
Cogumelo Ostra | Fresco
5,00 € – 80,00 €Price range: 5,00 € through 80,00 €Ver opções This product has multiple variants. The options may be chosen on the product page -
PROMOÇÃO !!! 
Cereal Esterilizado em Saco PP
4,00 € – 9,00 €Price range: 4,00 € through 9,00 €Ver opções This product has multiple variants. The options may be chosen on the product page -
PROMOÇÃO !!! 
Sacos para Cultivo – PP
18,00 € – 200,00 €Price range: 18,00 € through 200,00 €Ver opções This product has multiple variants. The options may be chosen on the product page -
PROMOÇÃO !!! 
Sacos para Spawn – PP
23,00 € – 300,00 €Price range: 23,00 € through 300,00 €Ver opções This product has multiple variants. The options may be chosen on the product page -
PROMOÇÃO !!! 
Cabo de Bisturi | Aço INOX
8,50 €O preço original era: 8,50 €.6,50 €O preço atual é: 6,50 €.Ver opções This product has multiple variants. The options may be chosen on the product page -
PROMOÇÃO !!! 
Mix Cultura Líquida (1L)
6,00 €O preço original era: 6,00 €.4,00 €O preço atual é: 4,00 €. -
PROMOÇÃO !!! 
Pack Seringa + Grão Esterilizado
18,00 € – 25,00 €Price range: 18,00 € through 25,00 €Ver opções This product has multiple variants. The options may be chosen on the product page -
PROMOÇÃO !!! 
Pack 5 Seringas Cultura Líquida
33,00 € – 80,00 €Price range: 33,00 € through 80,00 €Ver opções This product has multiple variants. The options may be chosen on the product page -
PROMOÇÃO !!! ![Frasco de Spawn Frasco de Spawn em Grão inoculado [100g]](https://goldencap.pt/wp-content/uploads/2025/12/Adobe-Express-file-500x500.png)
Frasco de Spawn em Grão inoculado [100g]
12,50 €O preço original era: 12,50 €.4,50 €O preço atual é: 4,50 €.Ver opções This product has multiple variants. The options may be chosen on the product page -
PROMOÇÃO !!!
Cultura Pura | Várias Espécies
25,00 €O preço original era: 25,00 €.20,00 €O preço atual é: 20,00 €.Ver opções This product has multiple variants. The options may be chosen on the product page -
PROMOÇÃO !!! 
Cavilhas inoculadas | Cogumelo Shiitake
8,50 € – 60,00 €Price range: 8,50 € through 60,00 €Ver opções This product has multiple variants. The options may be chosen on the product page -
PROMOÇÃO !!! 
Mix Cultura Sólida | 1L / 5L
5,00 € – 25,00 €Price range: 5,00 € through 25,00 €Ver opções This product has multiple variants. The options may be chosen on the product page -
PROMOÇÃO !!! 
Seringa de Cultura Líquida Viva | 10 ml / 20ml /50ml
9,50 € – 32,00 €Price range: 9,50 € through 32,00 €Ver opções This product has multiple variants. The options may be chosen on the product page -
PROMOÇÃO !!! 
Spawn de Cogumelos para Inoculação | Várias Espécies
9,50 € – 13,50 €Price range: 9,50 € through 13,50 €Ver opções This product has multiple variants. The options may be chosen on the product page